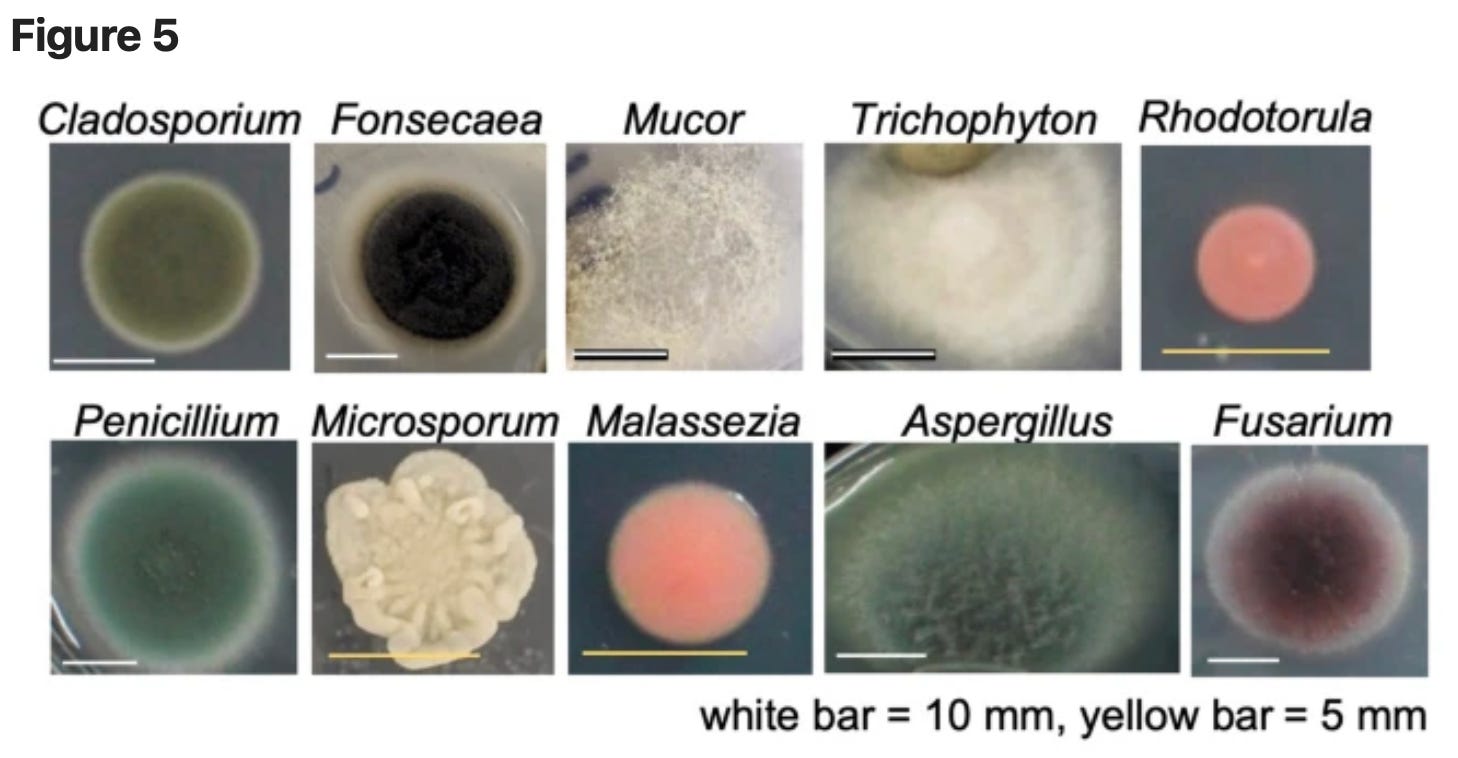

C&C. NUCLEAR CHICKEN. MASK & INFECTION? NYPS LOOSING STUDENTS?
July 19 | Posted by mrossol | American Thought, Biden, Childers, Education, Health, Russia, UkraineJeff Childers: Coffee & Covid ☙ Tuesday, July 19, 2022 ☙ CHICKEN
*COVID NEWS AND COMMENTARY*
🔥 The Economist ran a story yesterday headlined, “Is America Growing Weary of the Long War In Ukraine?” Well. I was immediately suspicious, because the Ukraine war hasn’t been that long, not really, not when compared to the war on covid or any other war, for that matter.
The Economist ruefully noted that “even Mr Biden’s closest allies are asking whether America might soon tire of the burden,” and admits that Biden “is more unpopular even than Donald Trump was at this point in his presidency.”
My gosh! More unpopular than President Trump! And even though he’s heroically opposing the Russians.
Late in the article, the Economist put its tobacco-stained finger right on the squidge that marks the real problem:
Mr. Biden’s aim in the war is unclear. His administration has stopped talking about helping Ukraine to “win”, and instead speaks of preventing it from being defeated.
That’s the problem, all right. What IS the goal, Joe? If it’s “winning,” what does that even look like and how do we get there?
Yesterday I wondered if it was time to try de-escalating the Ukraine conflict to lower the risk of global thermonuclear war, which somehow triggered some people in the comments. I could not understand why until I saw this explanation, from the article:
> For Ukraine’s supporters, whether Democratic or Republican, the answer is for Mr. Biden to hurry up and win: give Ukraine more military help, do it faster and accept more risk.
It seems the pro-war Ukrainians want the U.S. to just skip the messy middle and jump right into direct war with the Russians, to teach them a lesson or something. But the Russians have nuclear missiles and doomsday submarines and even nuclear torpoedos for goodness’ sake. A fully-kinetic global war won’t help the Ukrainians, at all. Probably just the opposite.
It’s magical thinking.
Speaking of magical thinking, there also now seems to be a partisan split. According to the article, Dems are more willing than Republicans to personally sacrifice to help the Ukrainians. “Among Democrats, 78% would accept costlier fuel and 72% would bear more inflation to help Ukraine; among Republicans only 44% and 39% respectively would do so.”
It’s too bad we can’t just have a voluntary bump in the income tax or something for everyone who wants to sacrifice for Ukraine. But I wonder if the split is really partisan so much as just reflecting which news source people usually rely on.
🔥 On Thursday, the U.S. Embassy in Kyiv warned all Americans to immediately leave Ukraine by “immediate departure through privately available ground transportation options.” Various social media reports say the Embassy closed Friday and no employees remain there.
What does the Embassy know? Is Russia about to take Kyiv, Ukraine’s capital city?
After advising people to avoid large groups that could become military targets, and to immediately seek cover if they hear loud explosions or air-raid sirens, the Embassy offered the helpful tip that fleeing Americans should stop to get the jab: “Get a COVID vaccine to facilitate your travel.”
🔥 The next story may possibly be the most significant news I’ve ever reported, and I don’t think I’m exaggerating. The news is that Deputy Chairwoman of the Russian State Duma (congress) Irina Yarovaya gave an update yesterday on Russia’s official investigation into US Biolabs in Ukraine.
What the Russians are saying isn’t pretty. And they claim to have a mountain of evidence. So far, the U.S. has not deigned to respond to any of the deadly serious allegations.
Remember that back in May, the Russians presented evidence to the U.N. Security Council arguing that the U.S. had been performing illegal bioweapons development — AND TESTING — in Ukraine, including accusing the last three Democrat administrations of working with George Soros, Bill Gates, and big pharma to break treaties, develop illegal weapons technology, release bioweapons into Ukraine, test the weapons on soldiers and mental patients, and — most significantly — infect the Russian people and crops.
Specifically, the Russians identified a surprising list of key individuals and groups alleged to have masterminded the conspiracy:
- The *Democratic National Party*
- *Barack Obama*
- *Hilary Clinton*
- *Joe Biden*
- *George Soros*
I am not making that up. That’s what the Russians are saying. A remarkable diagram shows all the alleged players that goes far beyond those named above, and includes Pfizer, the Bill and Melinda Gates Foundation, and others.
The Russians accused the top Democrats of facilitating the illegal research for military purposes in league with big pharma, which was brought in whenever there were tests or leaks, to develop lucrative treatments for the new diseases. In return, argued the Russians, big pharma funneled massive campaign contributions back to Democrats, making a sinister and demonic viral feedback loop.
U.S. corporate media — which furiously leapt on the made-up Russiagate story and for weeks breathlessly reported unsubstantiated allegations against Brett Kavenaugh — completely ignored the Russians’ incredibly serious accusations, fully discounting them as “Russian misinformation” to the point it wasn’t even worth mentioning. The Biden Administration even tried to setup a “disinformation governance board” run by a former Zelensky aid, in an apparent effort to screw an even tighter lid onto the news.
Last week, the Russians announced they intend to release a comprehensive report about the U.S. biolabs program soon — before the midterms — and yesterday, as I said, Chairwoman Yarovaya gave a status update to the Russian Duma, or legislature.
🔥 Yarovaya began her comments yesterday as follows:
“As evidence today, the parliamentary commission may already present the facts that bio laboratories supervised by the Pentagon on the territory of Ukraine did not meet safety criteria. In the current mode of their activity, they posed and pose a colossal threat for citizens of Ukraine and for the whole world.
The facility was not only insecure. Despite the fact that they were working with dangerous viruses and pathogens, there was also a leak. It is quite likely that this explains the growth of epidemics in Ukraine.
But most likely, those who created these laboratories were interested in ensuring [they] were not adequately protected, not only for corruption, but also in order to carry out a live experiment; in this way, to monitor what the reaction from the population would be, what the mortality rate would be, what the consequences would be.”
In other words, the Russians are saying the U.S. has been INTENTIONALLY negligent. The idea would be that the U.S. could deliberately leak pathogens and then hide behind the excuse it was just an accident, because everybody knows the labs are so shoddy. Like when your kids manically swings his arms around acting crazy and then “accidentally” punches his younger brother in the nose. Sorry not sorry!
The Russians’ theory sounds bonkers until you consider Wuhan. Starting in 2018, the State Department published a series of reports about how the biolab at the Wuhan Institute of Virology was so insecure and poorly-run. And then nothing whatever was done about it. Then the covid virus “accidentally” leaked and broke the world. So those State Department reports were retrospectively super helpful, in diverting suspicion that the virus was purposefully leaked.
It was just an accident.
The Russians also alleged that the U.S. culprits are hiding behind “animal research;” further concealing their guilt by genetically grafting human infection capabilities onto existing animal viruses, so they can claim natural origins for the newly-developed bugs. Like with covid. Or monkeypox.
If true, it would explain all the “veterinary reasearch” biolabs the U.S. has been building in all these third-world countries that lack oversight or effective supervision and what regulators there are, will — well — look the other way under the right circumstances. And probably pretty cheaply.
Yarovaya said the result of all this intentional negligence has been “unforeseen situations all over the world.” She fingered the U.S. for the novel monkeypox outbreak. “Everything related to coronavirus, monkey pox, should be searched in the test tubes of American laboratories,” she said.
By a totally random coincidence, the very same Wuhan Institute of Virology where covid was developed was also experimenting with monkeypox:
So.
🔥 Because the Russians are naming specific individuals, it is starting to look like the Russians plan to launch a Nuremberg-style international criminal complaint along the lines that so many Americans have been wishing for. It also looks like the Chinese are siding with the Russians. The Chinese have good reasons to side with the Russians.
A 2017 article published in the Journal of Health Security is titled, “Taiwan’s Public Health National Laboratory System: Success in Influenza Diagnosis and Surveillance.” It includes some interesting statistics.
Taiwan has about the same population as the State of Florida. But for some reason, the article reported that the country has “1,251 microbiological laboratories in a tiered system that addresses medical, agricultural, food, and environmental needs.” That seems like a lot of biolabs; it would be the equivalent of 18 biolabs in every county in Florida.
According to the article, Taiwan has “a national BSL-4 laboratory in northern Taiwan affiliated with the National Defense Medical Center.” In other words, it’s military. It also has 31 “national labs,” which “serve as reference centers for the fields of virology, bacteriology, parasitology, mycology, and vector biology.”
Vector biology is the study of carriers, like ticks and mosquitos, that can transmit infectious diseases to humans.
The Russian allegations, and the justification they create for the invasion of Ukraine, also create a neat justification for a Chinese invasion of Taiwan.
In her most recent Substack letter, doctor Naomi Wolfe — who has led the effort to crowdsource the Pfizer document dump review — claims to have discovered information showing that Pfizer is partly owned by the Chinese Communist Party, or at least that the CCP owns a major manufacturer of the mRNA drug.
Wolfe says her project has convinced her that we are already at war and just don’t realize it yet. Facing the Beast – Outspoken with Dr Naomi Wolf.
🔥 All these allegations — completely ignored by corporate media — are incredibly serious. The Russians are accusing the U.S. of a biological weapons of mass destruction attack. It has long been the official policy of the U.S. that a bioweapons attack is equivalent to a nuclear attack, and would justify a nuclear response.
It doesn’t matter whether they’re right. The Russians appear to believe they are legally justified in retaliating against the U.S. using weapons of mass destruction. And they’re building the case using a lot of shady stuff that the U.S. and its deep-state corporate allies have been up to.
It sure would be a good time for the U.S. government to speak up and get totally transparent about the legitimate purpose behind all these labs. Assuming there IS a legitimate purpose.
But perpetrators, whoever they are, would almost certainly risk nuclear war to protect their secrets if only half of what the Russians are saying is true. So, wittingly or not, we are all involved in a deadly game of nuclear chicken.
And our driver is Joe Biden.
In any event, it is looking even more likely that Naomi Wolfe is right, that the Third World War already started over two years ago in January 2020, with covid. We all thought WW3 would be fought with global thermonuclear war. But that style of warfare is simply too expensive, so warfare has obviously evolved, or mutated. This World War’s arsenal actually appears to be constructed out of biological weapons — and their mandated therapeutics.
😷 A new study published yesterday in Scientific Reports titled, “Bacterial And Fungal Isolation From Face Masks Under the COVID-19 Pandemic.”
Uh-oh!
The researchers surveyed 109 medical-school volunteers on their mask usage and lifestyles, and then cultured bacteria and fungi from the face-side and the outer-side of their masks. This will shock you, but they found bacteria and fungi growing on the masks.
Bacterial colonies were found on 99% of the samples on the face-side, and 94% on the outer-side. The researchers found fungal colonies growing on 79% of the samples on the face-side, and 95% on the outer-side. They also found that longer mask usage significantly increased the fungal colony figures (but not the bacterial colony numbers).
Although most of the bacteria were non-pathogenic, they found several potentially pathogenic bugs: S. aureus (commensal bacterium; its overgrowth can cause various diseases); B. cereus (intestinal bacterium, causing food poisoning); Staphylococcus saprophyticus (urinary tract infection); and Pseudomonas luteola (an opportunistic pathogen).
The researchers detected several types of fungus:
The conclusion? The authors suggested “that immunocompromised people should avoid repeated use of masks to prevent microbial infection.”
Haha! Thanks experts! Immunocompromised people are the ones the experts always say should wear masks the most — all the time, if they can. Can you believe by giving that advice the experts were actually setting immunocompromised people up for even worse infections? So which is it? Should immunocompromised people wear masks or not?
What would we do without experts?
💉 WBOY ran a story last week headlined, “Antimicrobial-Resistant Infections Up 15% During COVID, CDC says.” Tell me it isn’t so.
Antimicrobial resistance is when bacteria and fungus become resistant to antibiotics, antifungals and other treatments. The CDC published its special report last week titled, “COVID-19: U.S. Impact on Antimicrobial Resistance, Special Report 2022.” The special report concludes that the threat of antimicrobial-resistant infections has significantly increased since March 2020, with resistant hospital-onset infections AND DEATHS jumping +15% or more during the first year of the pandemic.
Some resistant bug strains increased a whole lot more than +15%. Carbapenem-resistant Acinetobacter saw a +78% increase, and multidrug-resistant Pseudomonas aeruginosa saw a +32% increase. Also up were Enterococcus (+14%) and Staphylococcus aureus, otherwise known as Mersa (MRSA) (+13%).
Now consider this odd fact: In its 2019 special report, the CDC said that antimicrobial-resistant infections had fallen by -27% during the entire period between 2012 to 2017. But the trend suddenly reversed in March 2020, for some reason.
It can’t have anything to do with the masks, can it? Just asking.
🔥 Emmaneul Macron’s odious Covid Passport was defeated in the French parliament last week, by a coalition of both left and right-wing populist parties. It’s a great example of what we can do when we put aside political differences and all work together.
📉 So this is crazy weird. The New York Post ran a story late last week headlined, “NYC Projects Enrollment Losses of Another 30,000 Students This Fall.” That can’t be good for business.
Mayor Adams told reporters that, “We have a massive hemorrhaging of students — massive hemorrhaging. We’re in a very dangerous place in the number of students that we are dropping.” By the end of the next school year, the district will be down to a total of 760,439 students.
According to the New York Department of Education, while its public schools have lost about -120,000 students over the last five years, for some reason New York’s charter schools have seen record GROWTH during the same time frame.
What could possibly explain this? Experts? Hello?
🔥 The Hill ran a story last week headlined, “U.S. Tourist Tumbles Into Mount Vesuvius After Trying to Snap Selfie.” I have to confess, I was worried for a minute that it was Joe Biden.
The tourist is okay. He hung on to a ledge until Italian park operators could lower a rope down and he scrambled back up. He lost his phone though. Lesson learned, I guess.
Have a terrific Tuesday! I’ll see you back here tomorrow for more.
If you can, help me get the truth out and spread optimism and hope: https://www.coffeeandcovid.com/p/-learn-how-to-get-involved-
Twitter: @jchilders98
Truth Social: @jchilders98
MeWe: mewe.com/i/coffee_and_covid.
C&C Swag! www.shopcoffeeandcovid.com
Emailed Daily Newsletter: https://www.coffeeandcovid.com

Leave a Reply
You must be logged in to post a comment.